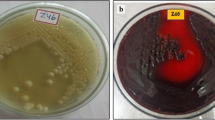

Abstract
Metals as a resource are depleting, and on another side, it fetches serious environmental pollution causing a threat to human health and ecosystem. The heavy metal accumulation due to anthropogenic activities results in toxicological manifestation. The traditional methods of remediation are not cost effective, efficient, and ecofriendly which necessitate and motivate towards the safe, effective, and ecofriendly biological methods. The increasing presence of heavy metals in the microbial habitat compels the microbes to develop the ability to tolerate or resist the presence of heavy metals. Exopolysaccharide (EPS) production is one of the strategies of microbes to fight against metal stress. EPS is a microbial biopolymer which is generally produced under stress from harsh environment and nutrition conditions. EPSs are cell-associated or secreted outside the cell and comprised organic macromolecules such as polysaccharides, proteins, and phospholipids in addition to some non-polymeric molecules. EPSs work as competent biosorbents with an anionic reactant group that effectively sequesters cationic heavy metals by electrostatic interactions. The present paper summarizes the EPSs with its types, role, and biosynthesis and an endeavor to elucidate the interaction mechanism of EPSs with heavy metal with supportive and distinctive applications for heavy metal exclusion. The review concluded with the current challenges and future prospects to make the EPS an efficient biosorbent.
Similar content being viewed by others
Explore related subjects
Discover the latest articles, news and stories from top researchers in related subjects.Avoid common mistakes on your manuscript.
Exopolysaccharide (EPS)
Exopolysaccharides (EPSs) are the polysaccharides of microbial origin that are secreted out of the cell [1]. Many microorganisms produce polysaccharides surrounding the cell which is made up of repeating sugar units. These are collectively termed as EPS, which is either tightly associated with the cell wall as capsular polysaccharides (CPS) or liberated into the medium as an unattached loose slime layer (ropy EPS) [2]. The biofilm-forming bacteria essentially produce EPS to combat the varying natural environmental conditions because they can get the nutrition and protection from the antibacterial agents and predators [3]. EPS attracts the attention of investigators as biofilm formers that can be used for onsite bioremediation of polluted sites [4]. The mucoid polysaccharides (EPS) that are released by bacteria have been shown to serve multiple functions including the promotion of the initial attachment of cells to solid surfaces; the development and continuance of microcolonies and mature long-lasting biofilm structures; water retention; the incorporation of exogenous organic compounds for gathering nutrients from the environment; and improved biofilm resistance to environmental strain and disinfectants [5, 6]. Irrespective of origin, EPSs are localized at or outside the cell surface of bacteria and are composed of organic macromolecules of varying high molecular weight compounds such as proteins, polysaccharides, phospholipids, and nucleic acids along with other non-polymeric constituents of low molecular weight [7]. They are best defined as bound and soluble EPSs on the basis of methods of extraction or separation rather than by their physical states [8]. The major constituents of EPS of microbial origin are carbohydrates and proteins [9]. However, some other organic compounds such as nucleic acids, uronic acids, and lipids as well as some inorganic compounds have been found in EPS [10,11,12,13]. Moreover, EPSs also contain divalent metal cations that act as ionic bridges linking adjacent polysaccharide chains. The acidic nature of the EPS is a result of the presence of uronic acids, pyruvate, and inorganic residues such as phosphate or sulfate [14,15,16,17]. Uronic acid plays an important role in metal binding [18]. The EPS composition varies with different microbial aggregates showing a heterogeneous nature [7]. This situation is related to many factors, such as extraction method, growth phase, culture environment, bioreactor type, process parameters, and analytical tools used [9, 19]. Many bacterial cultures produced different types of EPS during its life cycle like most bacteria which produce EPS in capsular form during the exponential growth phase while EPS of slime type during the stationary growth phase [7].
Types and Composition of EPS
Most of EPS-producing bacteria produce either homopolysaccharides or heteropolysaccharides. The homopolysaccharides contain repeating units of only one type of monosaccharide and include cellulose, dextran, mutan, alternan, pullulan, levan, and curdlan [20]. The heteropolysaccharides are composed of repeated subunits of different monosaccharides, derivatives of monosaccharides, or substituted monosaccharides [21]. The homopolysaccharides can be categorized based on linkage bond and monomer units present into β-d-glucans, α-d-glucans, polygalactan, and fructans. The heteropolysaccharide has d-glucose, d-galaxies, l-rhamnose, N-acetylgalactosamine or N-acetylglucosamine, or glucuronic acid as repeating units, and intermittently, there is the presence of non-carbohydrate substituents such as phosphate, acetyl, and glycerol [22].
Biosynthesis of homopolysaccharides requires specific substrates like sucrose which acts by a specific enzyme, for example, dextran, levan, or alternan, which are synthesized extracellularly by transglycosylases while the heteropolysaccharides are made intracellularly and then exported. The repeating sugar units are assembled by sugar-specific glycosyltransferases on the inner face of the cytoplasmic membrane from intracellular precursors and sequential transfer with isoprenoid glycosyl carrier lipids [23, 24].
The EPS has also been classified based on its function as sorptive, constructive or structural, surface-active, active, informative, redox-active, and nutritive [25]. The summary of some significant microbial EPS is described in Table 1.
EPS Production and Metal Stress
Different species of microorganisms have been assessed in terms of their ability to produce EPS [49,50,51,52]. Bacteria, fungi, and aquatic algae are reported for EPS production, but a major emphasis is given on bacterial EPS in the present study [53]. EPS is produced by both Gram-negative and Gram-positive bacteria, and EPS producers can be found in many different niches. The size and composition of EPS polymers are diverse and are often strain-dependent. The screening of EPS-producing bacterial strains basically depends upon the development of mucoid characteristics of bacterial colonies. The more mucoidal form of colonies produces more EPS. The release of EPS is an interesting process for the bacterium, which comprises hydrophilic, high molecular weight polymer assembly in the cytoplasm and its traverse through the cell envelope, without affecting the critical barrier to transport. Even if there is a wide diversity of molecular structures of different EPSs, their biosynthesis pathway and release in most of Gram-negative bacteria have been followed by either of the pathways: (i) the Wzx–Wzy-dependent pathway, wherein the polymer monomeric units are accumulated at the inner face of the cytoplasmic membrane and polymerized at the periplasm. While in a case of (ii) the ABC transporter-dependent pathway, polymerization takes place at the cytoplasmic face of the inner membrane [54]. (iii) The synthase-dependent pathway involves complete polymer strand secretion across the membrane and cell wall as well as polymerization and translocation of homopolymers contacting only one type of sugar precursor by a single synthase protein and (iv) extracellular synthesis by use of a single sucrase protein. These first three pathways have a stepwise elongation of polymer strands which occurred by enzymatic transformation inside the cells while in extracellular production, the polymer strand is elongated by direct addition of monosaccharides by cleavage of disaccharides or trisaccharides [23].
After taking into account the pathway of biosynthesis, we move ahead to the genetics of biosynthesis. The structural genes involved in polysaccharide biosynthesis are clustered and present in a large number of Gram-negative organisms. The strategies concerned to find out the genes involved including indirect and direct approaches. The indirect approach was based on prior isolation of mutants, but the major problem was that screening can pick up mutants whose altered phenotype is not caused by mutations in structural genes. While the direct or probe-based approach included identification of genes relying on the availability of DNA sequence information. These can be obtained by sequencing the N-terminal portion of purified proteins encoded by a gene. This approach is powerful and leads to rapid identification of the whole cluster of genes and no confusing groups of mutation to reform [55].
Based on the structure–function relationship, large clusters of biosynthetic genes are involved in various bacteria, for instance, Lactobacillus rhamnosus 18.5 kb encoding 17 ORFs [56]; Acetobacter xylinum 35.5 kb genomic fragment [57]; Pseudomonas solanacearum 6.5 kb gene cluster [58]; Eschwinia stewartii 10 kb gene cluster for capsular polysaccharide [59]; and many more. Xanthomonas campestris was discussed as an excellent model system because it was the only complete system wherein both biosynthetic genes and their enzymatic products are known. It was used as a mechanistic model for biosynthesis of xanthan and reported as a first large-scale metabolic model [60]. This verified metabolic model is also the first model focusing on bacterial EPS synthesis [61]. A pCHC3 plasmid of 12.4 kb contained a xanthan biosynthetic cluster along with ketal pyruvate transferase which increased the yield of polymer, and this gene was cloned and sequenced [62].
The microbial production of EPS is significantly influenced by many environmental factors such as temperature, pH level, medium composition, oxygen concentration, salt concentration, and/or heavy metal concentration. In the presence of an excess of carbon source and limited nitrogen, potassium, or phosphate, the EPS synthesis is promoted [14]. Many putative roles have been proposed for these polymers, such as protection against dehydration or UV radiation, phagocytosis, and biomineralization. It is known that the production of EPS takes place because of cellular stress. Therefore, as expected, adding metal ions to the growth media increased bacterial EPS production [18, 63].
Microorganisms respond to the presence of potentially toxic metal ions through several intrinsic mechanisms to regulate intracellular concentrations [64, 65], among which one of the important responses is EPS production. Toxic substances including heavy metals stimulated the production of EPS in Rhodopseudomonas acidophila but reduced the cell dry weight [66]. EPS is a non-living sorbent; as a result, it is preferred for its easy availability in the treatment process and avoidance of pathogenicity issues of the organism concerned [67]. The literature reported that fungi, algae, or bacterial cultures may remove toxic heavy metals through their EPS molecules [51, 68, 69].
Metal removal is independent of the colony size while dependent on the particular microorganism tested, the metal evaluated, and its concentration. The microbial affinity to metals in solid media was different from the removal in liquid media, probably due to metal distribution and availability [70]. Therefore, it is necessary to study the effect of individual factors on bacterial cells when used in bioremediation of toxic metals. Nevertheless, the scientific community has increased interest in the use of secreted EPS due to the abiotic nature of EPS and its manipulative nature to desired conditions at the metal contamination sites.
Current Approaches for Heavy Metal Removal
The phrase heavy metal is defined as metals and metalloids with an atomic density greater than 5 g cm−1. The term “toxic metal” is referred to the effect of these metals, particularly on the environment. Sometimes the term “toxic heavy metal” is used to emphasize the impact of these elements particularly on the biological system.
Heavy metals such as copper, zinc, and nickel are essential for life in low concentrations; these are also called as microelements or trace elements. Microelements play an important role in metabolic processes of living cells [64]. The raised levels of these metal ions are toxic to maximum prokaryotic and eukaryotic organisms. The other non-essential heavy metals like mercury, cadmium, and lead resulted in severe damage to organisms even at very low concentrations [71].
Metal as a kind of resource is becoming scarce and also brings about serious environmental pollution, intimidating ecosystem and human health [72]. The three classes of heavy metals classified the metals as toxic metals (such as Zn, Ni, Hg, Cr, Pb, Cu, Cd, As, Co, Sn, etc.), precious metals (such as Au, Pd, Pt, Ag, Ru etc.), and radionuclides (such as Th, U, Am, Ra, etc.) [73]. Heavy metals are stable in nature and persist in the environment as a contaminant since they cannot be degraded or destroyed. Consequently, the metal toxicity stands major health and environmental problems that necessitate the severe pursuit for economical and efficient technologies for metal-contaminated site remediation. Metal pollution and bioaccumulation or biomagnifications of metals cause serious health and ecological risk. Environments contaminated with heavy metals pose a significant problem, mainly due to the toxic effects of these metals throughout the food chain [72].
The traditional techniques for metal remediation comprised general physicochemical precipitation, such as induction of electrochemical treatment, reverse osmosis, ion exchange, chemical coagulation, and ultrafiltration. Nevertheless, these processes also have shortcomings and need to find suitable places. Furthermore, a majority of these methods are out of industrial-scale applications. Besides these, there is an involvement of high capital and operational costs, high energy utilization, and production of large amounts of toxic compounds containing sludge, which are not environmentally safe [69]. Therefore, biotechnological approaches which are cost effective and eco-friendly with high potential of toxic metal remediation are noteworthy to empower [74] (Fig. 1).
Bioremediation not only is a cost-effective solution but is also a safe and effective alternative. The microbial biomass proposes an attractive option for the removal and recovery of toxic but precious metal ions by the uptake and accumulation [75]. Bacteria among all forms of life have the superior competence to absorb metals from solutions due to highest surface-to-volume ratio [76]. Bacterial biosorbents have an effective metal sequestering property that can reduce the heavy metal concentration from the parts per million to the parts per billion level in a large volume of wastewater with very less metal ion concentration [73]. The excreted or derived microbial components from microbial cells have not given much attention instead of its important role in metal microbe interaction [77]. Therefore, it is time to go for the microbial components like EPS for heavy metal bioremediation.
Why EPS for Heavy Metal Removal?
The studies on EPS recommended the customized efforts from a state of production to the application. EPS is a potential tool that can lead to the development of a sustainable, economic, and environmentally friendly system for the removal of heavy metals. The traditional methods are not efficient and cost-effective to detect very less concentration of heavy metal ions. Hence, there is a need of alternate material or development of a method for the purpose of remediation of heavy metal-contaminated land or aquatic area [78].
The EPS production is associated with biofilm formation, and biofilm EPS plays an important role in the heavy metal bioremediation process [79]. The EPS production is one of the protective strategies for biofilm-forming bacteria to survive and grow in a metal-contaminated environment [8, 80]. The secreted form of EPS has its own importance from several decades in biosorption [81, 82]. The benefits of microbial EPS in contrast to plants, crustacea, or algae are related to their physicochemical properties and their fermentative production, i.e., it is not subjected to instability due to crop loss, marine pollution, or climate change [83]. The external parameters such as pH, type of metal, biomass concentration, and ionic strength of ions affect the metal biosorption capacity of EPS [84].
The EPS-producing bacteria were present in diverse environmental conditions and have different reactant groups which can be specifically explored to remove varying organic pollutants like herbicides [85]. The EPS is a result of a metabolism-independent process composed of organic and inorganic molecules which work for the accumulation of metal ions [80, 86, 87]. The secreted form of EPS has been recommended as a surface-active agent [69, 88]. EPS has a significantly higher ability to remove heavy metals when compared with EPS producing biomass. The EPS production was higher in the metal-containing medium; hence, heavy metal addition in the culture medium is recommended for maximum EPS production [18]. The metal adsorptive capacity of EPS of Lyngbya putealis is compared to its dry or immobilized biomass; the superior metal binding capacity was observed for EPS which proposed EPS as an efficient biosorbent [63].
It has been observed that enhanced accumulation of metal is linked to the higher amount of EPS production [89, 90]. Kazy et al. [90] noted that the presence of Cu ions in the growth medium stimulates fourfold EPS production in copper-resistant strains. The binding capacity of EPS of copper-resistant strains was also greater (320 mg/g) than EPS of copper-sensitive strains (270 mg/g). Pseudomonas marginalis high MRL (maximum resistance level) in the presence of lead is accompanied with high EPS production [84]. The role of EPS in a creation of intracellular deposits was confirmed for nickel uranyl phosphate deposition associated with Citrobacter sp. [91].
The physicochemical interaction between metal cation and functional groups established on ion exchange, physical sorption, complexation, and/or precipitation comprised the biosorption process [51, 92,93,94,95]. Heavy metals which are toxic to the microbial cell lead to the production of microbial exudates, e.g., EPS, which is the protective response against the toxic effect of heavy metals [66, 96, 97]. Cell walls of microbial biomass offer particularly abundant metal-binding functional groups. Besides these, the peptidoglycan of cell wall and/or cell wall-associated EPS (capsules and slimes) or proteinaceous S-layers can constitute effective biosorption matrices [98].
The exopolymeric biomass entraps dispersed solids and binds dissolved metals which offer the microenvironment with high concentration of CO2 and alkaline pH which could be beneficial for metal precipitation [84].
Toxic metals bind to biofilm EPS which facilitates metal transport and emancipates metal toxicity. Accordingly, the binding of EPS with heavy metal ions is accounted to be an important mechanism of detoxification of metal-polluted areas by bioremediation [99, 100]. The further advancement of EPS-based bioremediation could be initiated by immobilization of EPS on the regenerative matrix [101].
Apart from dry and immobilized biomass, the dead bacterial cell wall or cell wall-associated EPS might be exploited for biosorption and it could even be preserved and reused which leads to sustainable development [102]. The dead bacterial cell is employed to work as an inert support without maintaining the condition parameters and without spreading the living microbes in the environment. The EPS could bind with metal ions in dilute solution so it has more sensitivity for metal bioremediation [54].
Understanding the Interaction of EPS Producers with Heavy Metals
There are many numbers of studies that have been reported for use of microbial cell (living or dead) for the purpose of removal and recovery of metal ions [53, 88, 103, 104]. The metal binding mechanism has also been investigated up to a certain extent for the whole microbial cell [105]. Conversely, microbial excreted material or derived product has not been noticed much for its role in metal interaction or binding [106]. The metal binding generally occurs at the cell surface by producing various metabolites like polysaccharides or by some cell-derived products which are capable of uptake and accumulation of metal ions [76, 86, 87, 107]. Many scientists have reported the application of extracellular capsular polysaccharides from a microbial cell for their high adsorption capacity for metal ions [108, 109]. The exopolysaccharides (EPS) are the major constituents of exopolymers composed mainly of repeating sugar subunits. It is accepted that metal biosorption involves a physicochemical interaction between metal cation and functional groups established on ion exchange, physical sorption, complexation, and/or precipitation mechanisms [93]. The anionic property of EPS is due to the presence of negatively charged ionizable phosphate, carboxylate, acetate, amine, and more rarely sulfate groups, which in turn react with positively charged metal ions [92, 109]. The characteristics of the functional groups present on EPS from varying microorganisms are unique and need to be considered to understand the mechanism of metal chelation by EPS [63]. Amino functional groups in the polysaccharides contribute to the binding of heavy metals [108, 110]. The carboxyl or hydroxyl groups are moreover involved in the metal binding process by forming coordination bonds that give stability to metal ion polymer complexes [111]. The electrostatic interactions are involved in binding of cations to negatively charged functional groups, for example, uronic acid and phosphoryl groups associated with membrane components and carboxylic groups of amino acids. In addition to electrostatic interactions, cationic binding by positively charged polymers or coordination with hydroxyl groups may be present [112] (Fig. 2).
The role of EPS has some disagreement: in its role as a protective barrier for external metal load and that it adsorbs a significant amount of metal ions in the vicinity of the cell membrane. Consequently, it needs a detailed study to confirm the role of EPS, may be by varying the EPS proportion [113].
The resistance to heavy metal in microbes may be the result of avoidance, i.e., prevention of ability to uptake. The metal resistance is attained as a result of avoidance of entry of metal inside the cells by the adsorption of metal ions with cell components and/or cell wall-associated material at the cell surface [114,115,116,117,118], or the secreted form of metal-binding organic compounds like EPS to the surrounding environment [119,120,121]. Metal tolerance might be the consequence of an ability to cope with high amounts of heavy metals inside the tissues (tolerance), an active process that involves the entrance, uptake (absorption), and accumulation of the metal ions inside the cell.
The metal resistance is the surface phenomenon while the tolerance is the uptake and accumulation of metal inside the cell. The dual biosorption involved both secreted EPS and the cell wall or cell wall-associated EPS as observed in the case of Lysinibacillus sp. strain HG17 cultivated in the presence of 100 μM HgCl2 [102].
Exopolysaccharides and other biopolymers exhibit excellent metal-binding properties with a distinct degree of specificity and affinity; for example, cadmium may have a higher affinity for EPS than copper and zinc [64]. Even though EPSs have different affinities for different metals, the modification could be observed in EPS confirmation. The solution of multiple metal ions previously sorbed on the biomass exerts a strong hindrance to the entry of other ions at the adjacent adsorption sites by an alteration in the EPS confirmation [122,123,124]. The synergistic action between metals could also be explained the same way as sorption of high-affinity metal ions which induced an amendment of the specific binding sites for the lowest-affinity metal ions, thereby increasing their sorption ability [125]. Panwichian et al. [126] assumed that the metal ions bind to secreted EPS and hence not accumulated in the cells and so could be used as biosorbent to remove metal ions and justify the use of EPS for metal removal and protection of producing a microbial cell. The selectivity for metal binding sites of some EPS is being influenced by the level of acetylation [127]. In the presence of more than one metal, the process of metal binding to the cyanobacterial EPS can be non-interactive, synergistic, or competitive, depending on the metal ions and characteristics of the polysaccharide [128].
The binding of the metal ion to EPS which avoids entry of metals into the cell influences the metal homeostasis. The effect was explained by Pearson’s hard–soft acid base theory in which the biosorbent acts as a Lewis base and the metals act as a Lewis acid. The theory has classified the metal ions as class A (hard acids), class B (soft acids), or borderline, according to their affinity for different ligands [129, 130]. The electronegativity and radius of metal ion influence its affinity for the EPS-binding sites [131, 132].
The structural and compositional variations among EPSs from diverse microbial cells and aggregate biopolymers from planktonic cells, biofilms, activated sludge and biomass, and biogranules in metal biosorption and/or transformation are discussed by Pal and Paul [8] which in turn affect the EPS–metal interactions. Moreover, enzyme activities in EPS also help in the detoxification of heavy metals by transformation followed by precipitation in the polymer mass. In the case of aquatic microorganisms, bound EPSs chelate the metals and bind it to the cell surface [133]. The EPSs of aquatic microorganisms work as polyanions by forming a salt bridge with negatively charged carboxyl groups particularly EPSs containing uronic acid or electrostatic interactions with hydroxyl groups on neutral carbohydrates. The selectivity of EPSs to bind with specific metals does not have the obligation on the use of a type of macromolecule in metal binding as either proteins or nucleic acids or acidic amino acids or uronic acid may be involved in electrostatic interaction with cations [134]. Proteins rich in acidic amino acids, like aspartic and glutamic acids, are also responsible for the anionic properties of EPS [135] while the nucleic acids are polyanionic, as a result of the phosphate residues in the nucleotide moiety of EPS. Even uronic acids, acidic amino acids, and phosphate-containing nucleotides are probably involved in electrostatic interactions with multivalent cations [136]. Apart from this, the bacterial ability to transform metal into a less toxic form or dissolution of the mineral substrate also worked as a supportive mechanism.
In the case of microalgae, biosorption of metal ions is a biphasic process [137, 138]. The understanding of the metal binding mechanism will be useful for the development of a strategy for metal bioremediation. The first phase is adsorption by extracellular material, which is metabolism-independent and works in living as well as dead cells [76, 114, 115, 117, 139, 140]. While the second phase is absorption and accumulation inside the cell which is a slow process, composed of active transport, binding to proteins, and intracellular components. The second phase is metabolism-dependent and affected by temperature, energy sources, inhibitors, and uncouplers and hence occurs only in live cells [141]. However, high metal concentration and extreme pH are limiting factors for the use of live bacterial cells as a tool for bioremediation.
Potential Applications of EPS for Heavy Metal Bioremediation
There is a remarkable increase in the number of publications (research papers and reviews) dealing with the use of exopolysaccharide for heavy metal removal since the 1990s. [105]. It is accepted that naturally occurring biological methods are beneficial rather than the physicochemical techniques for remediation of lethal heavy metal ions. Exopolysaccharide-producing microbes are abundant in the environment with remarkable ability to take up and accumulate heavy metals from their surrounding environment.
At our laboratory at North Maharashtra University, India, we were involved in the screening of exopolysaccharide-producing isolates which were explored for heavy metal removal potential. The rhizospheric isolate was found effective for metal tolerance and biosorption of a number of heavy metals such as mercury, copper, cadmium, chromium, arsenic, silver, and lead (100 mg/L). The study for the representative metal, arsenic, is shown in Fig. 3. We also observed the morphological variation at the cell surface level under metal stress and confirmed that production of EPS was increased in metal stress conditions compared with untreated EPS production (unpublished).
The exopolysaccharide produced by Bacillus firmus was reported for the removal of copper, lead, and zinc from aqueous solutions [99] and Serratia sp. for cadmium removal [142]. EPS plays an important role in chromium (VI) tolerance and may also enhance chromium (VI) removal according to a study of Ozturk et al. [143].
Priester et al. [144] illustrated the increased level of extracellular carbohydrates, protein, DNA, and EPS sugars particularly N-acetylglucosamine, rhamnose, glucose, and mannose in Pseudomonas putida under chromium stress. Further, it was also confirmed that the cell lysis due to chromium toxicity is the reason for improved EPS production. In the cyanobacterial strain Synechocystis sp. BASO672 study, toxic chromium (VI) encouraged the microbial EPS production [143]. There were some reports on copper (II) and lead (II) adsorption by the EPS of cyanobacterial strains like Nostoc and Cyanospira [145] and Gloeocapsa gelatinosa [146], respectively.
When the EPS production by the mixed microorganisms in wastewater treatment systems from activated sludge was conducted to investigate the adsorption mechanism of EPS and its adsorption capacities on various heavy metals, subsequently it showed that more metals were removed by the EPS than by the activated sludge process despite the higher metal concentrations. This type of EPS contains large quantities of proteinaceous exoenzymes entrapped in the EPS matrix of the microorganisms in the activated sludge [11, 147]. These results suggested the feasibility of recovering EPS from waste sludge for use as adsorbent [148]. Bacteria of the genus Ochrobactrum have been reported to display metal biosorption properties through the production of exopolysaccharides which supports the mechanism of biosorption by secreted EPS [109]. Mokaddem et al. [149] projected the lead adsorption from aqueous solutions on agar beads with EPS produced from Paenibacillus polymyxa. Paenibacillus jamilae is able to use toxic olive-mill wastes as the fermentation substrate for EPS production which interacts with a number of heavy metals like lead, cadmium, cobalt, nickel, zinc, copper, and iron [150]. Thus, there is growing interest in EPS utilization for heavy metal removal. Some representative EPS producers with their metal binding potential are presented in Table 2.
Challenges and Future Prospects
Microbial exopolysaccharide is a versatile biomaterial. EPS and EPS-producing microbial species particularly bacteria in live or dead form were greatly explored for bioremediation of heavy metal as a fast, competent, sensitive, and economic system. Biosorption with EPS is a complex phenomenon. Many scientist and groups worked on individual metal removal efficiency of EPS while some tried for the metal solution in combination. But in order to apply for the actual field conditions where varying heavy metals and its forms are present, a thorough study is needed to understand the specificity and selectivity of heavy metals by EPS. The ionic nature, charge, and size of metal ions are responsible for its binding with EPS. The electrostatic binding of metal with EPS needs to be understood in depth. The biosorption is a physical, metabolism-independent mechanism which is affected by the physicochemical conditions; hence, these parameters should be taken into consideration. The studies considering these factors will lead to screening of a specific EPS-producing metal accumulator.
The reuse of EPS necessitates desorption after every use which may limit its use for not many times, as the efficiency may decrease on each use. EPS is complex in nature and is made up of protein, carbohydrate, and various other components. The exact role of each component and the interaction among the components need to be investigated for the metal binding potential. In order to bring the potential of EPS into application at the field, the study from the laboratory level to large volumes of metal-contaminated areas needed upscaling. The mechanism of interaction of EPS and metal ions should be investigated with diverse microbial sources and types of EPS. In conclusion, microbial exopolysaccharide snatches the amazing dive on the way to become an economic, sustainable, and environment-friendly biomaterial for bioremediation of heavy metals.
References
Ates, O. (2015). Systems biology of microbial exopolysaccharides production. Frontiers in Bioengineering and Biotechnology, 3, 200.
Cefalo, A. D. (2012). Characterization of the function and interaction of proteins involved in exopolysaccharide synthesis in Streptococcus thermophilus, Streptococcus iniae, and Lactococcus lactis subsp. cremoris. Utah State University.
Costerton, J. W. (1984). The role of bacterial exopolysaccharides in nature and disease. Developments in Industrial Microbiology, 26, 249–261.
Lappin-Scott, H. M., & Costerton, J. W. (1992). Ultramicrobacteria and their biotechnological applications. Current Opinion in Biotechnology, 3(3), 283–285.
Laspidou, C. S., & Rittmann, B. E. (2002). A unified theory for extracellular polymeric substances, soluble microbial products, and active and inert biomass. Water Research, 36(11), 2711–2720.
Czaczyk, K., & Myszka, K. (2007). Biosynthesis of extracellular polymeric substances (EPS) and its role in microbial biofilm formation. Polish Journal of Environmental Studies, 16(6), 799.
Wingender, J., Neu, T. R., & Flemming, H. C. (1999). What are bacterial extracellular polymeric substances? In Microbial extracellular polymeric substances (pp. 1–19). Berlin Heidelberg: Springer.
Pal, A., & Paul, A. K. (2008). Microbial extracellular polymeric substances: central elements in heavy metal bioremediation. Indian Journal of Microbiology, 48(1), 49.
Sheng, G. P., Yu, H. Q., & Li, X. Y. (2010). Extracellular polymeric substances (EPS) of microbial aggregates in biological wastewater treatment systems: a review. Biotechnology Advances, 28(6), 882–894.
Frølund, B., Palmgren, R., Keiding, K., & Nielsen, P. H. (1996). Extraction of extracellular polymers from activated sludge using a cation exchange resin. Water Research, 30(8), 1749–1758.
Dignac, M. F., Urbain, V., Rybacki, D., Bruchet, A., Snidaro, D., & Scribe, P. (1998). Chemical description of extracellular polymers: implication on activated sludge floc structure. Water Science and Technology, 38(8–9), 45–53.
d’Abzac, P., Bordas, F., Joussein, E., Hullebusch, E. V., Lens, P. N., & Guibaud, G. (2009). Characterization of the mineral fraction associated to extracellular polymeric substances (EPS) in anaerobic granular sludges. Environmental Science & Technology, 44(1), 412–418.
D’Abzac, P., Bordas, F., Van Hullebusch, E., Lens, P. N., & Guibaud, G. (2010). Extraction of extracellular polymeric substances (EPS) from anaerobic granular sludges: comparison of chemical and physical extraction protocols. Applied Microbiology and Biotechnology, 85(5), 1589–1599.
Sutherland, I. W. (1990). Biotechnology of microbial exopolysaccharides (Vol. 9). Cambridge University Press.
Majumdar, I., D'souza, F., & Bhosle, N. B. (2013). Microbial exopolysaccharides: effect on corrosion and partial chemical characterization. Journal of the Indian Institute of Science, 79(6), 539.
Larpin, S., Sauvageot, N., Pichereau, V., Laplace, J. M., & Auffray, Y. (2002). Biosynthesis of exopolysaccharide by a Bacillus licheniformis strain isolated from ropy cider. International Journal of Food Microbiology, 77(1), 1–9.
Tallon, R., Bressollier, P., & Urdaci, M. C. (2003). Isolation and characterization of two exopolysaccharides produced by Lactobacillus plantarum EP56. Research in Microbiology, 154(10), 705–712.
Dogan, N. M., Doganli, G. A., Dogan, G., & Bozkaya, O. (2015). Characterization of extracellular polysaccharides (EPS) produced by thermal Bacillus and determination of environmental conditions affecting exopolysaccharide production. International Journal of Environmental Research, 9(3), 1107–1116.
Nielsen, P. H., & Jahn, A. (1999). Extraction of EPS. In Microbial extracellular polymeric substances (pp. 49–72). Berlin Heidelberg: Springer.
Monsan, P., Bozonnet, S., Albenne, C., Joucla, G., Willemot, R. M., & Remaud-Siméon, M. (2001). Homopolysaccharides from lactic acid bacteria. International Dairy Journal, 11(9), 675–685.
De Vuyst, L., De Vin, F., Vaningelgem, F., & Degeest, B. (2001). Recent developments in the biosynthesis and applications of heteropolysaccharides from lactic acid bacteria. International Dairy Journal, 11(9), 687–707.
Sharon, N. (1966). Polysaccharides. Annual Review of Biochemistry, 35(1), 485–520.
Schmid, J., Sieber, V., & Rehm, B. (2015). Bacterial exopolysaccharides: biosynthesis pathways and engineering strategies. Frontiers in Microbiology, 6(496), 1–24.
Davis, J. K. (2012). Combining polysaccharide biosynthesis and transport in a single enzyme: dual-function cell wall glycan synthases. Frontiers in Plant Science, 3.
Flemming, H. C., & Wingender, J. (2010). The biofilm matrix. Nature Reviews. Microbiology, 8, 623–633.
Schatschneider, S., Persicke, M., Watt, S. A., Hublik, G., Pühler, A., Niehaus, K., & Vorhölter, F. J. (2013). Establishment, in silico analysis, and experimental verification of a large-scale metabolic network of the xanthan producing Xanthomonas campestris pv. campestris strain B100. Journal of Biotechnology, 167(2), 123–134.
Chivero, P., Gohtani, S., Yoshii, H., & Nakamura, A. (2015). Effect of xanthan and guar gums on the formation and stability of soy soluble polysaccharide oil-in-water emulsions. Food Research International, 70, 7–14.
Cho, H. M., & Yoo, B. (2015). Rheological characteristics of cold thickened beverages containing xanthan gum–based food thickeners used for dysphagia diets. Journal of the Academy of Nutrition and Dietetics, 115(1), 106–111.
Morris, V. J. (2006). Bacterial polysaccharides. In Food polysaccharides and their applications (pp. 413–454). CRC Press.
Sezer, A. D., Kazak, H., Öner, E. T., & Akbuğa, J. (2011). Levan-based nanocarrier system for peptide and protein drug delivery: optimization and influence of experimental parameters on the nanoparticle characteristics. Carbohydrate Polymers, 84(1), 358–363.
Sima, F., Mutlu, E. C., Eroglu, M. S., Sima, L. E., Serban, N., Ristoscu, C., Petrescu, S. M., Oner, E. T., & Mihailescu, I. U. (2011). Levan nanostructured thin films by MAPLE assembling. Biomacromolecules, 12(6), 2251–2256.
Sam, S., Kucukasik, F., Yenigun, O., Nicolaus, B., Oner, E. T., & Yukselen, M. A. (2011). Flocculating performances of exopolysaccharides produced by a halophilic bacterial strain cultivated on agro-industrial waste. Bioresource Technology, 102(2), 1788–1794.
Ahmad, N. H., Mustafa, S., & Che Man, Y. B. (2015). Microbial polysaccharides and their modification approaches: a review. International Journal of Food Properties, 18, 332–347.
Han, J., Hang, F., Guo, B., Liu, Z., You, C., & Wu, Z. (2014). Dextran synthesized by Leuconostoc mesenteroides BD1710 in tomato juice supplemented with sucrose. Carbohydrate Polymers, 112, 556–562.
Casettari, L., Bonacucina, G., Morris, G. A., Perinelli, D. R., Lucaioli, P., Cespi, M., & Palmieri, G. F. (2015). Dextran and its potential use as tablet excipient. Powder Technology, 273, 125–132.
Cheng, K. C., Demirci, A., & Catchmark, J. M. (2011). Pullulan: biosynthesis, production, and applications. Applied Microbiology and Biotechnology, 92(1), 29.
Ma, Z. C., Liu, N. N., Chi, Z., Liu, G. L., & Chi, Z. M. (2015). Genetic modification of the marine-isolated yeast Aureobasidium melanogenum. Marine Biotechnology, 17(4), 511–522.
Özcan, E., Sargın, S., & Göksungur, Y. (2014). Comparison of pullulan production performances of air-lift and bubble column bioreactors and optimization of process parameters in air-lift bioreactor. Biochemical Engineering Journal, 92, 9–15.
Yang, J., Sun, D., Li, J., Yang, X., Yu, J., Hao, Q., Wenming, L., Jianguo, L., Zhigang, Z., & Gu, J. (2009). In situ deposition of platinum nanoparticles on bacterial cellulose membranes and evaluation of PEM fuel cell performance. Electrochimica Acta, 54(26), 6300–6305.
Sun, D., Yang, J., & Wang, X. (2010). Bacterial cellulose/TiO2 hybrid nanofibers prepared by the surface hydrolysis method with molecular precision. Nanoscale, 2(2), 287–292.
Shah, J., & Brown, R. M. (2005). Towards electronic paper displays made from microbial cellulose. Applied Microbiology and Biotechnology, 66(4), 352–355.
Rehm, B. H. A., & Valla, S. (1997). Bacterial alginates: biosynthesis and applications. Applied Microbiology and Biotechnology, 48(3), 281–288.
Rehm, B. H. (2010). Bacterial polymers: biosynthesis, modifications and applications. Nature Reviews Microbiology, 8(8), 578–592.
Stasinopoulos, S. J., Fisher, P. R., Stone, B. A., & Stanisich, V. A. (1999). Detection of two loci involved in (1→ 3)-β-glucan (curdlan) biosynthesis by Agrobacterium sp. ATCC31749, and comparative sequence analysis of the putative curdlan synthase gene. Glycobiology, 9(1), 31–41.
Pollock, T. J. (1993). Gellan-related polysaccharides and the genus Sphingomonas. Microbiology, 139(8), 1939–1945.
Plank, J. (2005). Applications of biopolymers in construction engineering. Biopolymer online, 10, 29–30.
Dougherty, B. A., & Van de Rijn, I. (1994). Molecular characterization of has A from an operon required for hyaluronic acid synthesis in group A Streptococci. Journal of Biological Chemistry, 269(1), 169–175.
Thonard, J. C., Migliore, S. A., & Blustein, R. (1964). Isolation of hyaluronic acid from broth cultures of streptococci. Journal of Biological Chemistry, 239(3), 726–728.
Nicolaus, B., Lama, L., Panico, A., Moriello, V. S., Romano, I., & Gambacorta, A. (2002). Production and characterization of exopolysaccharides excreted by thermophilic bacteria from shallow, marine hydrothermal vents of Flegrean Ares (Italy). Systematic and Applied Microbiology, 25(3), 319–325.
Leppard, G. G., Droppo, I. G., West, M. M., & Liss, S. N. (2003). Compartmentalization of metals within the diverse colloidal matrices comprising activated sludge microbial flocs. Journal of Environmental Quality, 32(6), 2100–2108.
Guibaud, G., Comte, S., Bordas, F., Dupuy, S., & Baudu, M. (2005). Comparison of the complexation potential of extracellular polymeric substances (EPS), extracted from activated sludges and produced by pure bacteria strains, for cadmium, lead and nickel. Chemosphere, 59(5), 629–638.
Nandal, K., Sehrawat, A. R., Yadav, A. S., Vashishat, R. K., & Boora, K. S. (2005). High temperature-induced changes in exopolysaccharides, lipopolysaccharides and protein profile of heat-resistant mutants of Rhizobium sp (Cajanus). Microbiological Research, 160(4), 367–373.
Kratochvil, D., & Volesky, B. (1998). Advances in the biosorption of heavy metals. Trends in Biotechnology., 16(7), 291–300.
Cuthbertson, L., Mainprize, I. L., Naismith, J. H., & Whitfield, C. (2009). Pivotal roles of the outer membrane polysaccharide export and polysaccharide copolymerase protein families in export of extracellular polysaccharides in gram-negative bacteria. Microbiology and Molecular Biology Reviews, 73(1), 155–177.
Griffin, A. M., Edwards, K. J., Gasson, M. J., & Morris, V. J. (1996). Identification of structural genes involved in bacterial exopolysaccharide production. Biotechnology and Genetic Engineering Reviews, 13(1), 1–18.
Péant, B., LaPointe, G., Gilbert, C., Atlan, D., Ward, P., & Roy, D. (2005). Comparative analysis of the exopolysaccharide biosynthesis gene clusters from four strains of Lactobacillus rhamnosus. Microbiology, 151(6), 1839–1851.
Coplin, D. L., & Cook, D. (1990). Molecular genetics of extracellular polysaccharide biosynthesis in vascular phytopathogenic bacteria. Molecular Plant-Microbe Interactions, 3(5), 271–279.
Denny, T. P., Makini, F. W., & Brumbley, S. M. (1988). Characterization of Pseudomonas solanacearum Tn5 mutants deficient in extracellular polysaccharide. Molecular Plant-Microbe Interactions, 1(5), 215–223.
Coplin, D. L., & Majerczak, D. R. (1990). Extracellular polysaccharide genes in Erwinia stewartii: directed mutagenesis and complementation analysis. Mol. Plant-Microbe Interact, 3, 286–292.
Vorhölter, F. J., Schneiker, S., Goesmann, A., Krause, L., Bekel, T., Kaiser, O., Linke, B., Patschkowski, T., Rückert, C., Schmid, J., & Sidhu, V. K. (2008). The genome of Xanthomonas campestris pv. Campestris B100 and its use for the reconstruction of metabolic pathways involved in xanthan biosynthesis. Journal of Biotechnology, 134(1), 33–45.
Schatschneider, S., Marcus, P., Steven, A. W., Gerd, H., Alfred, P., Karsten, N., & Frank-Jörg, V. (2013). Establishment in silico analysis, and experimental verification of a large-scale metabolic network of the xanthan producing Xanthomonas campestris pv.Campestris strain B100. Journal of Biotechnology, 167(2), 123–134.
Marzocca, M. P., Harding, N. E., Petroni, E. A., Cleary, J. M., & Ielpi, L. (1991). Location and cloning of the ketal pyruvate transferase gene of Xanthomonas campestris. Journal of Bacteriology, 173(23), 7519–7524.
Sharma, M., Kaushik, A., Bala, K., & Kamra, A. (2008). Sequestration of chromium by exopolysaccharides of Nostoc and Gloeocapsa from dilute aqueous solutions. Journal of Hazardous Materials, 157(2), 315–318.
Gadd, G. M. (1992). Molecular biology and biotechnology of microbial interactions with organic and inorganic heavy metal compounds.
Silver, S., & Phung, L. T. (1996). Bacterial heavy metal resistance: new surprises. Annual Reviews in Microbiology, 50(1), 753–789.
Sheng, G. P., Yu, H. Q., & Yue, Z. B. (2005). Production of extracellular polymeric substances from Rhodopseudomonas acidophila in the presence of toxic substances. Applied Microbiology and Biotechnology, 69(2), 216–222.
Gavrilescu, M. (2004). Removal of heavy metals from the environment by biosorption. Engineering in Life Sciences, 4, 219–232.
Omar, N. B., Merroun, M. L., Penalver, J. M. A., & Munoz, M. T. G. (1997). Comparative heavy metal biosorption study of brewer yeast and Myxococcus Xanthus biomass. Chemosphere, 35(10), 2277–2283.
Iyer, A., Mody, K., & Jha, B. (2005). Accumulation of hexavalent chromium by an exopolysaccharide producing marine Enterobacter cloaceae. Marine Pollution Bulletin, 49(11), 974–977.
Cruz-Vega D., Cervantes-González E., Ammons D., Rojas-Avelizapa L.I., García-Mena J., Pless R.C., Rojasavelizapa N.G. (2008). Tolerance and removal of metals by microorganisms isolated from a pitch lake. Proceedings of the 1st International Conference on Hazardous Waste Management, 117–118.
Christie, N. T., & Costa, M. (1984). In vitro assessment of the toxicity of metal compounds. Biological Trace Element Research, 6(2), 139–158.
Tchounwou, P. B., Yedjou, C. G., Patlolla, A. K., & Sutton, D. J. (2012). Heavy metal toxicity and the environment. In Molecular, clinical and environmental toxicology, pp. 133-164. Springer Basel.
Wang, J., & Chen, C. (2006). Biosorption of heavy metals by Saccharomyces cerevisiae: a review. Biotechnology Advances, 24(5), 427–451.
Chen, J. Z., Tao, X. C., Xu, J., Zhang, T., & Liu, Z. L. (2005). Biosorption of lead, cadmium and mercury by immobilized Microcystis aeruginosa in a column. Process Biochemistry, 40(12), 3675–3679.
Ross, D. (1990). Slurry-phase bioremediation: case studies and cost comparisons. Remediation Journal, 1(1), 61–74.
Beveridge, T. J. (1989). Role of cellular design in bacterial metal accumulation and mineralization. Annual Reviews in Microbiology, 43(1), 147–171.
Volesky, B. (2001). Detoxification of metal-bearing effluents: biosorption for the next century. Hydrometallurgy, 59(2), 203–216.
Huang, C., & Huang, C. P. (1996). Application of Aspergillus oryze and Rhizopus oryzae for Cu (II) removal. Water Research, 30(9), 1985–1990.
Baker-Austin, C., Wright, M. S., Stepanauskas, R., & McArthur, J. V. (2006). Co-selection of antibiotic and metal resistance. Trends in Microbiology, 14(4), 176–182.
Lau, T. C., Wu, X. A., Chua, H., Qian, P. Y., & Wong, P. K. (2005). Effect of exopolysaccharides on the adsorption of metal ions by Pseudomonas sp. CU-1. Water Science and Technology, 52(7), 63–68.
Brown, M. J., & Lester, J. N. (1979). Metal removal in activated sludge: the role of bacterial extracellular polymers. Water Research, 13(9), 817–837.
Nichols, C. M., Guezennec, J., & Bowman, J. P. (2005). Bacterial exopolysaccharides from extreme marine environments with special consideration of the southern ocean, sea ice, and deep-sea hydrothermal vents: a review. Marine Biotechnology, 7(4), 253–271.
Guezennec, J. (2002). Deep-sea hydrothermal vents: a new source of innovative bacterial exopolysaccharides of biotechnological interest? Journal of Industrial Microbiology & Biotechnology, 29(4), 204–208.
Malik, A. (2004). Metal bioremediation through growing cells. Environment International, 30(2), 261–278.
Shen, C. F., Kosaric, N., & Blaszczyk, R. (1993). The effect of selected heavy metals (Ni, Co and Fe) on anaerobic granules and their extracellular polymeric substance (EPS). Water Research, 27(1), 25–33.
Kelly, R. A., & Pekar, H. G. (1979). U.S. Patent No. 4,165,242. Washington, DC: U.S. Patent and Trademark Office.
Brierley, J. A., Goyak, G. M., & Brierley, C. L. (1986). Considerations for commercial use of natural products for metals recovery. Immobilization of ions by biosorption, 105–117.
Pandi, M., Shashirekha, V., & Swamy, M. (2009). Bioabsorption of chromium from retan chrome liquor by Cyanobacteria. Microbiological Research, 164(4), 420–428.
Roane, T. M. (1999). Lead resistance in two bacterial isolates from heavy metal–contaminated soils. Microbial Ecology, 37(3), 218–224.
Kazy, S. K., Sar, P., Singh, S. P., Sen, A. K., & D'souza, S. (2002). Extracellular polysaccharides of a copper-sensitive and a copper-resistant Pseudomonas aeruginosa strain: synthesis, chemical nature and copper binding. World Journal of Microbiology and Biotechnology, 18(6), 583–588.
Basnakova, G., Spencer, A. J., Palsgard, E., Grime, G. W., & Macaskie, L. E. (1998). Identification of the nickel uranyl phosphate deposits on Citrobacter sp. cells by electron microscopy with electron probe X-ray microanalysis and by proton-induced X-ray emission. Environmental Science & Technology, 32(6), 760–765.
Liu, H., & Fang, H. H. (2002). Characterization of electrostatic binding sites of extracellular polymers by linear programming analysis of titration data. Biotechnology and Bioengineering, 80(7), 806–811.
Gadd, G. M., & White, C. (1989). Uptake and intracellular compartmentation of thorium in Saccharomyces cerevisiae. Environmental Pollution, 61(3), 187–197.
Tourney, J., Ngwenya, B. T., Mosselmans, J. F., & Magennis, M. (2009). Physical and chemical effects of extracellular polymers (EPS) on Zn adsorption to Bacillus licheniformis S-86. Journal of Colloid and Interface Science, 337(2), 381–389.
Kantar, C., Demiray, H., & Dogan, N. M. (2011). Role of microbial exopolymeric substances (EPS) on chromium sorption and transport in heterogeneous subsurface soils: II. Binding of Cr (III) in EPS/soil system. Chemosphere, 82(10), 1496–1505.
Aquino, S. F., & Stuckey, D. C. (2004). Soluble microbial products formation in anaerobic chemostats in the presence of toxic compounds. Water Research, 38(2), 255–266.
Kılıç, N. K., & Dönmez, G. (2008). Environmental conditions affecting exopolysaccharide production by Pseudomonas aeruginosa, Micrococcus sp., and Ochrobactrum sp. Journal of Hazardous Materials, 154(1), 1019–1024.
Vijayaraghavan, K., & Yun, Y. S. (2008). Bacterial biosorbents and biosorption. Biotechnology Advances, 26(3), 266–291.
Salehizadeh, H., & Shojaosadati, S. A. (2003). Removal of metal ions from aqueous solution by polysaccharide produced from Bacillus firmus. Water Research, 37(17), 4231–4235.
Kachlany, S. C., Levery, S. B., Kim, J. S., Reuhs, B. L., Lion, L. W., & Ghiorse, W. C. (2001). Structure and carbohydrate analysis of the exopolysaccharide capsule of Pseudomonas putida G7. Environmental Microbiology, 3(12), 774–784.
Deschatre, M., Ghillebaert, F., Guezennec, J., & Simon-Colin, C. (2015). Study of biosorption of copper and silver by marine bacterial exopolysaccharides. WIT Transactions on Ecology and the Environment, 196, 549–559.
François, F., Lombard, C., Guigner, J. M., Soreau, P., Brian-Jaisson, F., Martino, G., Vandervennet, M., Garcia, D., Molinier, A. L., Pignol, D., Peduzzi, J., & Peduzzi, J. (2012). Isolation and characterization of environmental bacteria capable of extracellular biosorption of mercury. Applied and Environmental Microbiology, 78(4), 1097–1106.
Choudhary, M., Kumar, R., Datta, A., Nehra, V., & Garg, N. (2017). Bioremediation of heavy metals by microbes. In Bioremediation of Salt Affected Soils: An Indian Perspective, pp. 233–255. Springer International Publishing.
Ayangbenro, A. S., & Babalola, O. O. (2017). A new strategy for heavy metal polluted environments: a review of microbial biosorbents. International Journal of Environmental Research and Public Health, 14(1), 94.
Volesky, B., & Holan, Z. R. (1995). Biosorption of heavy metals. Biotechnology Progress, 11(3), 235–250.
Volesky, B. (1987). Biosorbents for metal recovery. Trends in Biotechnology, 5(4), 96–101.
Wong, P. K., & Kwok, S. C. (1992). Accumulation of nickel ion by immobilized cells of Enterobacter species. Biotechnology Letters, 14(7), 629–634.
Loaëc, M., Olier, R., & Guezennec, J. (1997). Uptake of lead, cadmium and zinc by a novel bacterial exopolysaccharide. Water Research, 31(5), 1171–1179.
Ozdemir, G., Ozturk, T., Ceyhan, N., Isler, R., & Cosar, T. (2003). Heavy metal biosorption by biomass of Ochrobactrum anthropi producing exopolysaccharide in activated sludge. Bioresource Technology, 90(1), 71–74.
Mittelman, M. W., & Geesey, G. G. (1985). Copper-binding characteristics of exopolymers from a freshwater-sediment bacterium. Applied and Environmental Microbiology, 49(4), 846–851.
Cozzi, D., Desideri, P. G., & Lepri, L. (1969). The mechanism of ion exchange with algenic acid. Journal of Chromatography A, 40, 130–137.
Gutnick, D. L., & Bach, H. (2000). Engineering bacterial biopolymers for the biosorption of heavy metals; new products and novel formulations. Applied Microbiology and Biotechnology, 54(4), 451–460.
González, A. G., Shirokova, L. S., Pokrovsky, O. S., Emnova, E. E., Martínez, R. E., Santana-Casiano, J. M., González-Davilla, M., & Pokrovski, G. S. (2010). Adsorption of copper on Pseudomonas aureofaciens: protective role of surface exopolysaccharides. Journal of Colloid and Interface Science, 350(1), 305–314.
Kaplan, D., Christiaen, D., & Arad, S. M. (1987). Chelating properties of extracellular polysaccharides from Chlorella spp. Applied and Environmental Microbiology, 53(12), 2953–2956.
Xue, H. B., Stumm, W., & Sigg, L. (1988). The binding of heavy metals to algal surfaces. Water Research, 22(7), 917–926.
Das, B. K., Roy, A., Koschorreck, M., Mandal, S. M., Wendt-Potthoff, K., & Bhattacharya, J. (2009). Occurrence and role of algae and fungi in acid mine drainage environment with special reference to metals and sulfate immobilization. Water Research, 43(4), 883–894.
De Philippis, R., Colica, G., & Micheletti, E. (2011). Exopolysaccharide-producing cyanobacteria in heavy metal removal from water: molecular basis and practical applicability of the biosorption process. Applied Microbiology and Biotechnology, 92(4), 697.
Naja, G., & Volesky, B. (2011). The mechanism of metal cation and anion biosorption. In: P. Kotrba, M. Mackova, T. Macek (Eds.), Microbial biosorption of metals (pp. 19–58). Dordrecht: Springer.
McKnight, D. M., & Morel, F. M. (1979). Release of weak and strong copper-complexing agents by algae. Limnology and Oceanography, 24(5), 823–837.
Berg, C. V. D., Wong, P. T. S., & Chau, Y. K. (1979). Measurement of complexing materials excreted from algae and their ability to ameliorate copper toxicity. Journal of the Fisheries Board of Canada, 36(8), 901–905.
Levy, J. L., Angel, B. M., Stauber, J. L., Poon, W. L., Simpson, S. L., Cheng, S. H., & Jolley, D. F. (2008). Uptake and internalisation of copper by three marine microalgae: comparison of copper-sensitive and copper-tolerant species. Aquatic Toxicology, 89(2), 82–93.
Sağ, Y., Kaya, A., & Kutsal, T. (2000). Lead, copper and zinc biosorption from bicomponent systems modelled by empirical Freundlich isotherm. Applied Microbiology and Biotechnology, 53(3), 338–341.
Tien, C. J. (2002). Biosorption of metal ions by freshwater algae with different surface characteristics. Process Biochemistry, 38(4), 605–613.
Parker, D. L., Mihalick, J. E., Plude, J. L., Plude, M. J., Clark, T. P., Egan, L., et al. (2000). Sorption of metals by extracellular polymers from the cyanobacterium Microcystis aeruginosa fo. flos-aquae strain C3-40. Journal of Applied Phycology, 12(3–5), 219–224.
Chen, J. P., & Yang, L. (2005). Chemical modification of Sargassum sp. for prevention of organic leaching and enhancement of uptake during metal biosorption. Industrial & Engineering Chemistry Research, 44(26), 9931–9942.
Panwichian, S., Kantachote, D., Wittayaweerasak, B., & Mallavarapu, M. (2011). Removal of heavy metals by exopolymeric substances produced by resistant purple nonsulfur bacteria isolated from contaminated shrimp ponds. Electronic Journal of Biotechnology, 14(4), 2–2.
Sutherland, I.W. (1983). Extracellular polysaccharides. In: Rehm HJ & Reed G (Eds.), Biotechnology: biomass, microorganisms for special applications, microbial products I, energy from renewable resources, pp. 531–574.
Micheletti, E., Colica, G., Viti, C., Tamagnini, P., & De Philippis, R. (2008). Selectivity in the heavy metal removal by exopolysaccharide-producing Cyanobacteria. Journal of Applied Microbiology, 105(1), 88–94.
Pearon, R. G. (1963). Of the American Chemical Society. Journal of the American Chemical Society, 85(22), 3533–3539.
Pearon, R. G. (1968). Hard and soft acids and bases. HSAB, part II: underlying theories. Journal of Chemical Education, 45(10), 643.
Can, C., & Jianlong, W. (2007). Correlating metal ionic characteristics with biosorption capacity using QSAR model. Chemosphere, 69(10), 1610–1616.
Neiboer, E., & Rishardson, D. H. (1980). The replacement of the nondescript term ‘heavy metals’ by a biologically and chemically significant classification of metal ions. Environmental Pollution Series B, Chemical and Physical, 1(1), 3–26.
Santamaría, M., Díaz-Marrero, A. R., Hernández, J., Gutiérrez-Navarro, A. M., & Corzo, J. (2003). Effect of thorium on the growth and capsule morphology of Bradyrhizobium. Environmental Microbiology, 5(10), 916–924.
Geesey, G. G., & Jang, L. (1989). Interactions between metal ions and capsular polymers. Metal ions and bacteria, 325–357.
Mejáre, M., & Bülow, L. (2001). Metal-binding proteins and peptides in bioremediation and phytoremediation of heavy metals. Trends in Biotechnology, 19(2), 67–73.
Beech, I. B., & Sunner, J. (2004). Biocorrosion: towards understanding interactions between biofilms and metals. Current Opinion in Biotechnology, 15(3), 181–186.
Roy, D., Greenlaw, P. N., & Shane, B. S. (1993). Adsorption of heavy metals by green algae and ground rice hulls. Journal of Environmental Science & Health Part A, 28(1), 37–50.
Das, N., Vimala, R., & Karthika, P. (2008). Biosorption of heavy metals—an overview. Indian Journal of Biotechnology, 7, 159–169.
Mishra, A., Kavita, K., & Jha, B. (2011). Characterization of extracellular polymeric substances produced by micro-algae Dunaliella salina. Carbohydrate Polymers, 83(2), 852–857.
Beveridge, T.J. (1988) “Wall structure: How little we know” In Antibiotic inhibition of bacterial cell surface assembly and function. In: P. Actor, L. Daneo-Moore, M.L. Higgins, M.R.J. Salton, G.D. Shockman (Eds.), Am. Soc. Microbiol., Washington, DC, 1988, p. 3.
Wilde, E. W., & Benemann, J. R. (1993). Bioremoval of heavy metals by the use of microalgae. Biotechnology Advances, 11(4), 781–812.
Valdman E., Gomes S., & Caldas S. (2005). Effect of biosurfactant concentration on cadmium biosorption by Serratia sp. Isolated from a tropical soil. In Comunicação Técnica ao XIII International Conference on Heavy Metals in the Environment.
Ozturk, S., Aslim, B., & Suludere, Z. (2009). Evaluation of chromium (VI) removal behaviour by two isolates of Synechocystis sp. in terms of exopolysaccharide (EPS) production and monomer composition. Bioresource Technology, 100(23), 5588–5593.
Priester, J. H., Olson, S. G., Webb, S. M., Neu, M. P., Hersman, L. E., & Holden, P. A. (2006). Enhanced exopolymer production and chromium stabilization in Pseudomonas putida unsaturated biofilms. Applied and Environmental Microbiology, 72(3), 1988–1996.
De Philippis, R., Paperi, R., & Sili, C. (2007). Heavy metal sorption by released polysaccharides and whole cultures of two exopolysaccharide-producing Cyanobacteria. Biodegradation, 18(2), 181–187.
Raungsomboon, S., Chidthaisong, A., Bunnag, B., Inthorn, D., & Harvey, N. W. (2006). Production, composition and Pb2+ adsorption characteristics of capsular polysaccharides extracted from a Cyanobacterium G. gelatinosa. Water Research, 40(20), 3759–3766.
Frolund, B., Griebe, T., & Nielsen, P. H. (1995). Enzymatic activities in the activated sludge floc matrix. Applied Microbiology and Biotechnology, 43(4), 755–761.
Liu, Y., Lam, M. C., & Fang, H. H. P. (2001). Adsorption of heavy metals by EPS of activated sludge. Water science and technology., 43(6), 59–66.
Mokaddem, H., Azouaou, N., Kaci, Y., & Sadaoui, Z. (2014). Study of lead adsorption from aqueous solutions on agar beads with EPS produced from Paenibacillus Polymyxa. Chemical Engineering Transactions, 38, 31–36.
Morillo, J. A., Aguilera, M., Ramos-Cormenzana, A., & Monteoliva-Sánchez, M. (2006). Production of a metal binding exopolysaccharide by Paenibacillus jamilae using two-phase olive-mill waste as fermentation substrate. Current Microbiology, 53(3), 189–193.
Rasulov, B. A., Yili, A., & Aisa, H. A. (2013). Biosorption of metal ions by exopolysaccharide produced by Azotobacter chroococcum XU1. Journal of Environmental Protection. 4(9), article ID 36802. In 5 pages.
Kavitha, V., Radhakrishnan, N., Gnanamani, A., & Mandal, A. B. (2011). Management of chromium induced oxidative stress by marine Bacillus licheniformis. Biology and Medicine, 3(2) special issue), 16–26.
Prado Acosta, M., Valdman, E., Leite, S. G., Battaglini, F., & Ruzal, S. M. (2005). Biosorption of copper by Paenibacillus polymyxa cells and their exopolysaccharide. World Journal of Microbiology and Biotechnology, 21(6), 1157–1163.
Ozdemir, G., Ceyhan, N., Ozturka, T., Akirmak, F., & Cosar, T. (2004). Biosorption of chromium (VI), cadmium (II) and copper (II) by Pantoea sp. TEM18. Chemical Engineering Journal, 102(3), 249–253.
Ozturk, A. (2007). Removal of nickel from aqueous solution by the bacterium Bacillus thuringiensis. Journal of Hazardous Materials, 147(1), 518–523.
Beech, I. B., & Cheung, C. W. S. (1995). Interactions of exopolymers produced by sulphate reducing bacteria with metal ions. Int Biodeter Biodegrad, 35(1–3), 59–72.
Acknowledgements
The author BVM is thankful to the Science and Engineering Research Board (SERB) for financial support under the Start-Up Research Grant (Young Scientist) File No. YSS/2015/001722.
Author information
Authors and Affiliations
Corresponding author
Rights and permissions
About this article
Cite this article
Mohite, B.V., Koli, S.H., Narkhede, C.P. et al. Prospective of Microbial Exopolysaccharide for Heavy Metal Exclusion. Appl Biochem Biotechnol 183, 582–600 (2017). https://doi.org/10.1007/s12010-017-2591-4
Received:
Accepted:
Published:
Issue Date:
DOI: https://doi.org/10.1007/s12010-017-2591-4